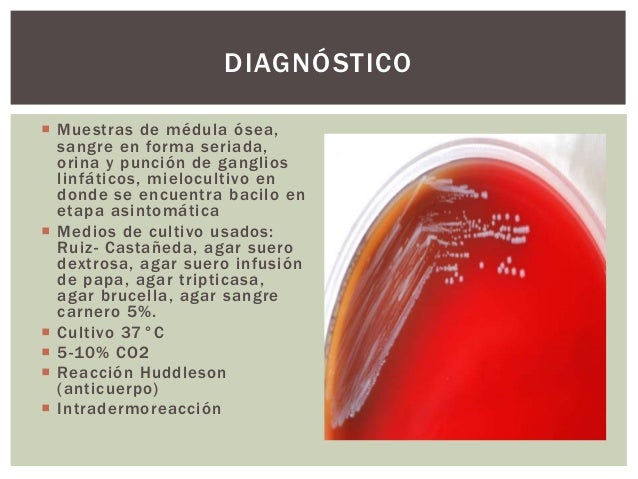
Brucella

If you are searching about Free picture: gram, negative, brucella abortus, bacteria, grown, blood agar you've visit to the right web. We have 9 Pics about Free picture: gram, negative, brucella abortus, bacteria, grown, blood agar like Free picture: gram, negative, brucella abortus, bacteria, grown, blood agar, Brucella Melitensis - Banco de fotos e imágenes de stock - iStock and also Brucella. Here it is:
Free Picture: Gram, Negative, Brucella Abortus, Bacteria, Grown, Blood Agar

brucella agar abortus blood gram bacteria negative grown medium brucellosis sheeps sba microscopy science pixnio
Free Picture: Brucella Suis, Infection, Granuloma, Necrosis, Brucellosis

brucella brucellosis granuloma necrosis
Brucellosis

brucellosis abortus biotypes
Mendoza Bajó Casi Un 70 % La Prevalencia De Brucelosis En Cabras

Brucella Melitensis - Banco De Fotos E Imágenes De Stock - IStock
Brucella
brucella
Brucella
brucella negatif boyama brucellosis 3mila ammalati fuga brucellosi batteri microbiology brucelosis färbung lichtmikroskop bacterianas infecciones evitar vacuna innecesario mejoras ganado
The Vet Planet: Brucellosis

brucellosis vet moderate pathogenicity
Free Picture: Gram, Negative, Burkholderia, Pseudomallei, Bacteria
burkholderia agar pseudomallei bacteria blood gram negative medium grown mallei colony glanders clostridium morphology positive plate microscopy pixnio science colonial
Brucella melitensis. Free picture: gram, negative, burkholderia, pseudomallei, bacteria. Burkholderia agar pseudomallei bacteria blood gram negative medium grown mallei colony glanders clostridium morphology positive plate microscopy pixnio science colonial